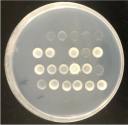

植物の窒素や硫黄等の養分吸収や植物体内での代謝の分子機構及び作物への土壌微生物を利用した養分供給機構を研究しています。
クリーンベンチ操作

シロイヌナズナの栽培

根粒菌
ゼミの様子

研究テーマ
最新情報 Topics
(本研究室メンバーが筆頭著者である論文の掲載や学会賞受賞について)
-
・2025.10.16 当研究室博士課程学生さんを筆頭著者とする国際共著論文が、Scientific Reportsに掲載されました。本研究で単離された高温、乾燥下でも植物の成長を促進できる微生物について、農業における資材化を目指しています。・2025.9.18 大津(大鎌)直子教授が第70回日本土壌肥料学会学会賞を受賞し、受賞記念講演を行いました。多くの皆様からのご支援により頂けた賞だと考えております。誠にありがとうございました。
・2025.6.11当研究室で行われた修士論文研究であり、Wrocław University of Environmental and Life SciencesおよびLeibniz Centre for Agricultural Landscape Research (ZALF)等との国際共同研究が、Plantsに掲載されました。
・2025.3.6 本研究室名誉教授横山正先生や修了生で福島大学の研究員となられた方を中心としたプロジェクト研究が、Biocatalysis and Agricultural Biotechnologyに掲載されました。
・2024.8.27当研究で学位を取得しタイ国カセサート大学の教員になられた研究者との国際共著論文が、Plant Science誌に掲載されました。
・2024.6.16当研究博士課程学生を筆頭著者とする国際共著論文が、microorganisms誌に掲載されました。
・2024.5.31当研究博士課程学生を筆頭著者とする農工融合研究の論文が、Sustainabilityに掲載されました。
・2024.3.5 当研究室の多くの学生さんが貢献した論文が、The Plant Journalに掲載されました。理化学研究所、九州大学、東京大学との共同研究です。
・2024.2.19 本研究室博士課程学生と特任助教が共同筆頭著者の論文が、Plant and Cell Physiologyに掲載されました。
・2023.9.13本研究室卒業論文研究成果の論文が、日本土壌肥料学会英文誌Soil Science and Plant Nutrition (SSPN) Awardを受賞しました。
・2023.5.3当研究室において博士課程学生の指導の下、卒論生が行った研究が、Microorganismsに掲載されました。
・2023.1.28当研究室博士課程学生が執筆した総説が、Journal of Experimental Botanyに掲載されました。
・2022.11.17当研究室で行われた博士論文研究が、Microorganismsに掲載されました。
・2022.9.27当研究室特任助教の論文が、Agronomyに掲載されました。
・2022.8.18当研究室での修士論文研究の一部がSoil Science and Plant Nurtirionに掲載されました。
・2022.8.1当研究室博士課程学生を筆頭著者とする論文が、Plant Journalに掲載され、プレスリリースされました。
・2022.3.21
当研究室博士課程学生の論文が、Microbes and Environmentsに掲載されました。
・2022.2.27
当研究室博士課程学生がAgVenture Lab主催「学生ビジネスプランコンテスト」で、“優秀賞”と
“スポンサー賞”の二冠を獲得しました。
・2022.1.27
当研究室博士課程学生の論文がMicrobes and Environmentsに掲載されました。
・2021.12.6
本研究室における修士論文研究が、Soil Science and Plant Nutritionに掲載されました。
・当研究室博士課程の学生がBS12 夢らぼ(番組HP:http://www.yume-lab.jp)に出演します。(令和3年12月11日(土)18:55-19:00 / 再放送:12月18日(土)18:55-19:00)
・2021.9.10本研究室修士課程学生が植物微生物研究会第30回研究交流会学生優秀発表賞を受賞しました。
・2021.7.20国際イノベーション農学プログラム学生との共同研究がSoil Science and Plant Nutritionに
掲載されました。
・2021.6.28本研究室修士課程学生が、日本土壌微生物学会優秀ポスター賞を受賞しました。
・2021.6.1本研究室修士課程学生が、FEMS CONGRESS ATTENDANCE GRANTSを受賞しました。
本研究室博士課程学生が、FEMS CONGRESS ATTENDANCE GRANTSを受賞しました。
・2021. 5. 29本研究室博士課程学生の論文が、Agronomy Journalに掲載されました。
・2021. 4. 24本研究室卒業論文の成果が、Soil Science and Plant Nutritionに掲載されました。
・2021. 1. 24本研究室博士課程学生の論文が、Plant Scienceに掲載されました。

